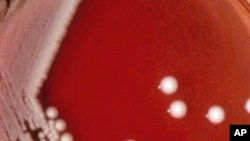
Carbapenem-resistant Klebsiella pneumoniae bacteria

As the World Health Organization prepares to mark World Health Day April 7, the U.N. agency is urging stepped-up international efforts to address the problem of antibiotic-resistant bacteria, which are posing increasingly serious public health threats, especially in hospitals. Here is our first of two reports.
"The scary part about these cases are it's a bacteria that is pretty common but develops resistance to most of the antibiotics we have," said Dr. Andrew Fishmann. "These are usually in patients who had previously been in a nursing home or other hospitals or have seen a course of antibiotics or several courses of antibiotics and as a result the bacteria becomes resistant to most of the antibiotics we use.''
Doctor Andrew Fishmann is referring to a potent bacterium called carbapenem-resistant Klebsiella pneumoniae - CRKP for short - that infected over 350 mostly elderly patients in California between June and December of 2010. Forty percent of these patients died within a month of becoming infected.
The germ in this case is resistant not only to the antibiotic carbapenem but to all other available antimicrobial drugs.
This strain of superbug has been reported in 35 states in the United States, but it's also caused infections in Argentina and Brazil, 15 of them fatal.
And it's just one of a growing number of dangerous bacteria that are proving resistant to mankind's arsenal of antibiotic drugs. The effectiveness of that arsenal, medical experts say, is dwindling fast because of widespread use and misuse of antibiotics.
"Antimicrobial resistance is increasing worldwide not only for specific antibiotics but for every antibiotic in every disease and not only for humans but also for antibiotics used in animals," said Dr. Marcos Espinal. "When you talk about TB, malaria, HIV but also diseases like pneumonia, diarrheal diseases - there is antimicrobial resistance all across the spectrum."
Dr. Marcos Espinal, who manages health surveillance, disease prevention and control at WHO, is heading up a campaign to educate patients, practitioners, and the general public about the spread of antimicrobial resistance in the Americas.
Underscoring the seriousness of the problem - not just in the Americas but around the globe - the World Health Organization has made anti-microbial resistance the theme of this year's World Health Day observance on April 7. The W.H.O. wants the international community to step up efforts to identify and combat these dangerous new superbugs.
The message is alarming. Even the most powerful antibiotics may fail against these superbug strains.
Hospitals are the most common breeding grounds of superbugs. But they can spread quickly within community settings as well.
Dr. Espinal says many a times infections go undetected because more sophisticated techniques are needed to detect these potentially deadly superbugs.
"Sometimes they are happening and we are not detecting them," he said. "There is always the reporting issue is very common in resource limited countries. They don’t have all the necessary tools and types of laboratories required to do that."
The Klabsiella pneumonia bacteria, like other superbugs, are highly contagious. They can be spread from an infected patient to other people by a simple touch, or with a cough or sneeze. And they can quickly bring down an infected person's immune system - allowing a host of other germs to invade the body.
"When a person is infected or develops antimicrobial resistance to a specific antibiotic - an umbrella of situations could happen," said Espinal. "The person can have the most negative outcome could die if not treated in time or the person could struggle by being sick and by spreading the disease for a long time like somebody with TB."
In today's interconnected world, with millions of travelers jetting every day to all corners of the globe, bacteria can be spread faster than ever. Public health experts are calling for stricter disease surveillance, better patient monitoring systems, and the establishment of special committees in hospitals to enforce more rigorous hygiene and sanitation standards.
Doctors advise that frequent hand-washing, patient isolation rooms and more selective use of antibiotics can help stop the spread of superbugs.
Experts agree that the world needs a new class of antibiotics to beat the superbugs down. But they warn that doctors and patients must learn to use these new weapons more carefully.
"Remember: developing new antibiotics will also require the development of new microbiological techniques to detect microbial resistance to those new antibiotics," said Espinal. "It’s a multipurpose initiative."
Dr. Espinal says that a new line of antibiotics will help cure the infected patients but without a change of medical practices, it will not solve the problem of antimicrobial resistance.
WHO calls the growing incidence of superbug infections a major burden on society that's causing death, suffering, disability, and higher health care costs - a major challenge the medical community must face without delay.
[In Part 2 of our report on the menace of drug-resistant bacteria, we look at the intensifying efforts by medical researchers to develop new and more effective antibiotics.]